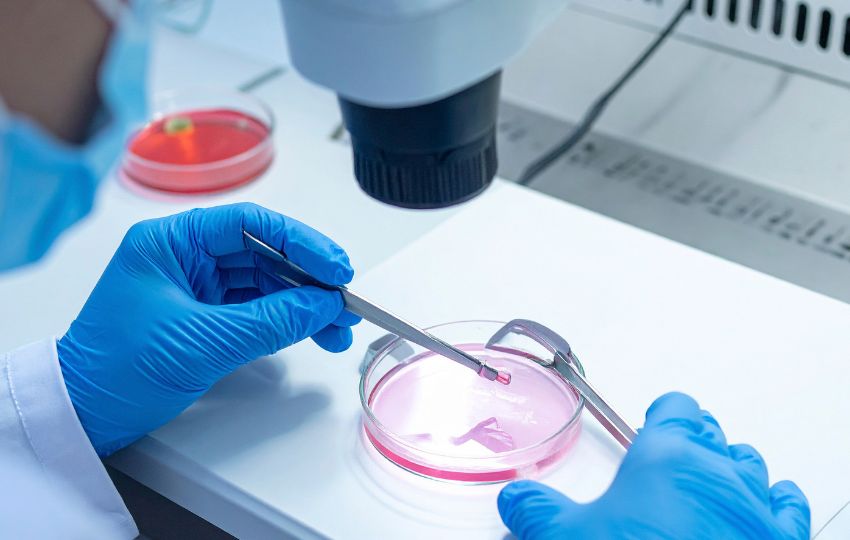
período periconcepcional

O período periconcepcional é uma fase pouco estudada, mas essencial para compreender a gravidez e, em especial, os fatores que levam a resultados adversos. A pesquisa sobre gravidez é complexa pela interação de três ambientes — materno, fetal e externo — e ainda enfrenta um desafio temporal: trata-se de um processo dinâmico, no qual estudos realizados em apenas um ou alguns momentos limitam a compreensão das complexas adaptações longitudinais da gestação.
Período periconcepcional e modificação endometrial
O período periconcepcional é o período imediatamente anterior à concepção, abrangendo também as primeiras semanas de gravidez. A preparação local para a implantação bem-sucedida do óvulo fertilizado, as interações imunológicas e os mecanismos de implantação devem estar em sincronia para uma gravidez bem-sucedida.
A decídua é o endométrio modificado da gravidez, e sua modificação começa na fase secretora do ciclo menstrual (pré-decidualização). Esse processo envolve alterações nas células imunes, no epitélio glandular e nas artérias espirais, que se intensificam após a implantação (decidualização).


Evidências moleculares e implicações na pré-eclâmpsia
Em um estudo, foram analisados 132 tecidos de biópsia de vilo corial (BVC) excedentes, dos quais quatro eram de mulheres que desenvolveram pré-eclâmpsia (PE) com características graves na gravidez posterior. A comparação da expressão gênica global entre essas mulheres e aquelas com desfecho normal (NP) revelou 171 genes diferencialmente expressos.
Os pesquisadores complementaram a análise com experimentos in silico baseados em bancos de dados transcriptômicos, comparando os resultados obtidos do trofoblasto misto viloso/extraviloso (EVT) e da decídua com tecidos de endométrio cíclico normal (sem EVT, sem decídua), de gestações ectópicas/tubárias (sem EVT) e de gestações intrauterinas precoces (com EVT e decídua).
Foram identificados 396 genes diferencialmente expressos entre os grupos PE e NP-BVC, sendo 154 associados a diferentes estágios de maturação endometrial.
Além disso, 16 genes normalmente suprarregulados em células NK deciduais e 25 genes em macrófagos deciduais estavam infrarregulados nas amostras de mulheres com pré-eclâmpsia.
Outro estudo demonstrou que, quando comparado ao de mulheres com gestações prévias normais, o soro obtido na fase mesosecretora de mulheres com histórico de pré-eclâmpsia grave prejudicou a decidualização de células estromais endometriais em cultura.
Esses achados sugerem que, além da disfunção endometrial intrínseca, fatores circulantes presentes em mulheres com antecedente de pré-eclâmpsia podem comprometer ainda mais a maturação endometrial durante a fase secretora.


Imunologia da placentação
As diferenças genéticas — e, portanto, imunológicas — entre a mãe e o bebê, que se encontram no contato íntimo entre placenta e útero, têm sido objeto de intenso estudo. As interações entre as células imunes uterinas e a placenta em implantação provavelmente são determinantes em muitos distúrbios da placentação, como abortos espontâneos recorrentes, natimortos inexplicáveis, pré-eclâmpsia e restrição do crescimento fetal (RCF).
Na decídua, destacam-se células imunes especializadas antes chamadas de granulócitos endometriais, mas atualmente conhecidas como células uterinas natural killer (uNK). Elas representam cerca de 70% dos leucócitos deciduais, são reguladas por hormônios e estão associadas temporal e espacialmente à implantação.
Apesar do nome, possuem baixa capacidade citotóxica, mas são uma rica fonte de citocinas (como CSF-1 e GM-CSF) e expressam receptores que reconhecem ligantes HLA-E, -C e -G nas células trofoblásticas invasoras.


Entre as diversas interações moleculares, o par HLA-C paterno (no trofoblasto) e KIR materno (nas células uNK) é especialmente relevante, pois ambos são altamente polimórficos. Isso levanta uma questão importante: existem combinações específicas de KIR materno e HLA-C fetal associadas a distúrbios da gravidez?
Evidências sugerem que sim.
Em uma população do Reino Unido, cerca de 30% dos homens de ascendência europeia apresentam o alelo C2+ HLA-C. Mulheres cujos bebês herdaram esse alelo paterno têm risco aumentado de desenvolver pré-eclâmpsia, a menos que também expressem o receptor KIR2DS1 (presente em aproximadamente 40% das mulheres).
Em outras populações, os KIRs ativadores e inibitórios podem variar, mas padrões semelhantes de associação entre combinações HLA-C/KIR e desfechos gestacionais também são observados, refletindo o papel crítico dessas interações na placentação saudável.


Infertilidade e reprodução assistida: influências nos resultados da gravidez
Entre 1997 e 2020, houve um aumento de 4,5 vezes no número de ciclos de fertilização in vitro (FIV).
Atualmente, cerca de 38% de todos os ciclos de FIV envolvem congelamento total de embriões, sem intenção imediata de transferência, enquanto 62% correspondem a ciclos de FIV a fresco. Torna-se cada vez mais evidente que as diferentes abordagens de FIV não são isentas de riscos.
Um dos principais desafios na avaliação dos riscos da tecnologia de reprodução assistida (TRA) é que a subfertilidade — motivo que leva à utilização da TRA — já está, por si só, associada ao aumento de resultados adversos na gravidez.
Outro ponto relevante é a implantação de mais de um embrião: embora se saiba que a transferência de múltiplos embriões aumenta a morbidade materna e perinatal em gestações múltiplas, apenas 40% dos ciclos de TRA são realizados com implantação única.
Considerando esses fatores, observa-se um risco 1,5 a 2 vezes maior de parto prematuro, pré-eclâmpsia, baixo peso ao nascer, restrição de crescimento fetal, mortalidade fetal e perinatal e patologia placentária em gestações obtidas por TRA — especialmente quando há transferência de múltiplos embriões resultando em nascimentos únicos. Além disso, há aumento de alterações epigenéticas em gestações por TRA que não podem ser explicadas apenas pela subfertilidade associada.


O uso de embriões congelados tem se tornado cada vez mais comum. Embora não se observe aumento evidente de parto prematuro, baixo peso ao nascer, restrição de crescimento, natimortalidade ou mortalidade perinatal, há maior frequência de pré-eclâmpsia em mães que utilizaram embriões congelados.
Outro achado importante é o dobro da taxa de sangramento — refletido pelo maior número de transfusões sanguíneas — entre mulheres que receberam embriões congelados, em comparação com aquelas que receberam embriões frescos.
O risco do congelamento também se estende ao feto concebido por essa técnica. Quando comparados com irmãos concebidos a partir de embriões não congelados, os irmãos gerados de embriões congelados apresentaram peso 70% maior.
Assim, as diferentes abordagens de reprodução assistida e os resultados variáveis associados a cada uma delas podem oferecer importantes insights sobre a fisiologia periconcepcional e, ao mesmo tempo, orientar modificações que aumentem a segurança dos procedimentos reprodutivos.


Mecanismos potenciais pelos quais as TRA levam a resultados adversos na gravidez
Fases normais da metilação do DNA
No desenvolvimento normal, existem três fases genômicas principais na programação da metilação do DNA:
Fase 1 – Apagamento (Desmetilação): ocorre durante a gametogênese, quando os alelos parentais sofrem desmetilação universal do DNA.
Fase 2 – Aquisição (Remarcação): o DNA é novamente “marcado” por metilação específica do sexo, definindo as assinaturas epigenéticas maternas e paternas.
Fase 3 – Manutenção: após a fertilização, os alelos parentais específicos em genes imprintados mantêm seu estado de metilação, enquanto a maioria das outras sequências genômicas é desmetilada.
Os procedimentos de tecnologia de reprodução assistida (TRA) podem se sobrepor às fases de Aquisição e Manutenção, períodos críticos da regulação epigenética embrionária.


Modelos experimentais e impacto da superovulação
Estudos em modelos murinos avaliaram genes que, quando regulados de forma aberrante, estão associados a síndromes de imprinting. Foi investigado se uma prática comum das TRAs — a superovulação induzida por hormônios (estimulação ovariana) — causaria perda de metilação do DNA em alelos imprintados de embriões no estágio de blastocisto.
Os pesquisadores observaram uma redução da metilação do DNA dependente da dose em três genes metilados pela mãe, e um gene controle, normalmente inativado pelo pai, também apresentou redução da metilação com a superovulação. Propôs-se que esse efeito resultaria da interferência da TRA na fase de Aquisição (para alelos maternos) e na fase de Manutenção (para o alelo paterno).
No entanto, ao se examinar o impacto da superovulação em oócitos, não houve diferença significativa na metilação dos alelos maternos, sugerindo que a fase de Aquisição ocorreu normalmente. Esses achados indicam que a superovulação afeta um fator materno essencial para a fase de Manutenção da metilação.


Efeitos da cultura embrionária in vitro
Foram também analisados os efeitos da cultura de embriões in vitro, com embriões cultivados do estágio de 2 células ao de blastocisto. O impacto da superovulação e da cultura embrionária, avaliados individualmente e em conjunto, foi estudado em três genes associados a distúrbios de imprinting.
Os resultados mostraram que ambos os procedimentos causaram alterações na metilação do DNA, e que, quando combinados, geraram um número ainda maior de embriões com metilação aberrante.

Alterações epigenéticas durante a gestação
Estudos posteriores, realizados no dia 9,5 da gestação, analisaram embriões resultantes de superovulação, cultura embrionária e transferência de embriões. Foi observada redução da metilação do DNA predominantemente na placenta, em comparação com o embrião propriamente dito.
Todos os grupos apresentaram supercrescimento placentário e redução da metilação do DNA, exceto o grupo de mórula para blastocisto, indicando que os efeitos das TRAs se concentram entre os estágios de 4 células e mórula.
As TRAs, portanto, parecem interromper fatores de efeito materno nos oócitos, essenciais para a manutenção da metilação por imprinting nos embriões durante os estágios de 4 a 8 células.


Perspectivas futuras
As evidências de que diferentes meios de cultura também produzem metilação aberrante do DNA, ainda que em intensidades distintas, mostram a complexidade do fenômeno. Essa complexidade exigirá estratégias moleculares de investigação direcionadas a embriões individuais.
No futuro, será essencial elucidar os mecanismos moleculares que regulam a metilação por imprinting nos estágios iniciais do desenvolvimento, e compreender como e quando as TRAs interferem nesses processos.
Esse conhecimento poderá aperfeiçoar as técnicas de reprodução assistida, reduzindo a ocorrência de embriões com perturbações de imprinting, e, consequentemente, a frequência de distúrbios epigenéticos e resultados adversos na gravidez.


Conclusão
Os dados apresentados reforçam a relevância crítica do período periconcepcional para o estabelecimento de uma gestação saudável e para a determinação dos desfechos gestacionais.
A decídua exerce papel central nesse processo, ao sustentar a implantação normal e prover nutrição inicial, fatores de crescimento e oxigênio ao embrião.
Além disso, as interações imunológicas entre o embrião e a decídua modulam os eventos precoces da placentação, sendo influenciadas pela variabilidade dos genes HLA-C expressos pelo trofoblasto fetal e pelo sistema genético KIR das células uNK maternas, que regulam a ativação trofoblástica.
Diante disso, é fundamental ampliar o foco dos estudos e da prática clínica para o período periconcepcional.
A prevenção de complicações gestacionais, por meio da compreensão e manejo precoce dos mecanismos envolvidos nesse estágio, pode representar uma estratégia mais eficaz e sustentável do que as intervenções terapêuticas instituídas após o estabelecimento das complicações.


—
Referências:
Roberts, J. M., Burton, G. J., Conrad, K. P., Luke, B., Mann, M. R., Moffett, A., & Jancsura, M. K. (2025). An overview of periconceptional pathology and pathophysiology: Where do we go next?. Placenta, 168, 98–110. https://doi.org/10.1016/j.placenta.2025.06.010

































